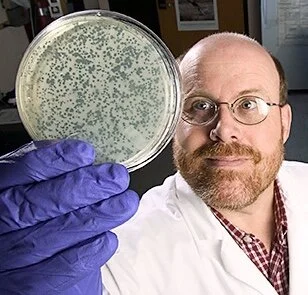

SCOUT MICROBIOLOGY’S STORY
Scout Microbiology LLC was formed in 2020 by Dr. Gregory R. Siragusa to offer consulting microbiology services for R&D, discovery, analytical, process/product development and troubleshooting.
Dr. Siragusa is a Fellow of the American Academy of Microbiology with over 30 years of experience as a research microbiologist in government research labs (Agricultural Research Service), private industry R&D and academia. Working in the ARS, Agtech Products, Danisco, DuPont and Eurofins have all contributed to a broad food safety, microbiology and biotechnical skill set. His record of innovative science, level of professionalism and creative problem solving is noted by peers.
Apply the right tools for the job, contact Scout Microbiology to work with you to yield practical solutions to your issues and ideas.
